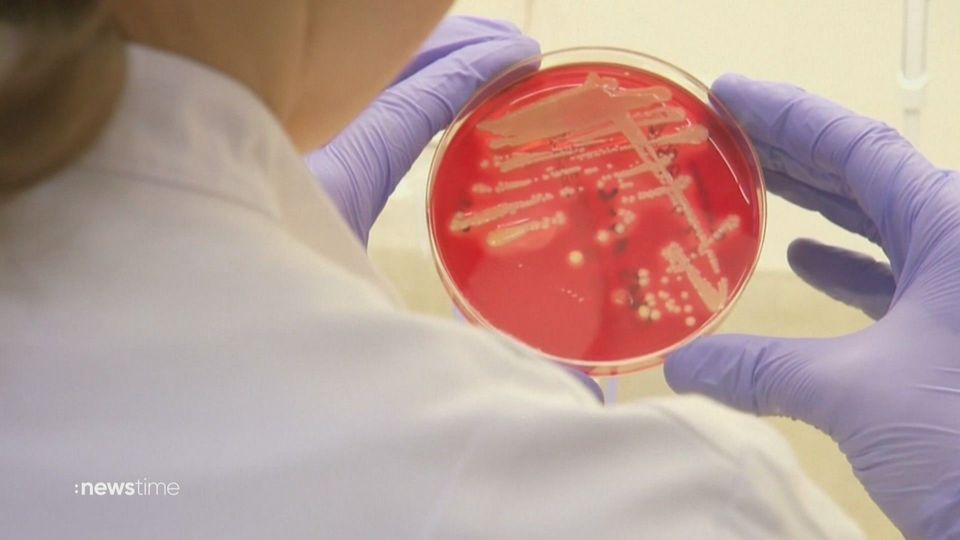
Forschende entwickeln neues Antibiotikum gegen multiresistente Keime

News

Homeoffice auf dem Rückzug? Firmen mit strengeren Vorgaben
Einfacheres Zeitmanagement, bessere Work-Life-Balance: Viele Bürobeschäftigte profitieren von großzügigen Home-Office-Regelungen. Einige namhafte Unternehmen schlagen nun jedoch einen strengeren Ton an.

Sonnenfinsternis 2024: Darum könnte sie dramatisch werden
Die totale Sonnenfinsternis vom 8. April bleibt von Mitteleuropa aus unbeobachtbar. Dennoch ist der Tag besonders…

Fans in Sorge wegen kryptischer Posts: Was macht eigentlich Samu Haber?
Fans von Ex-Sunrise-Avenue-Sänger Samu Haber waren ratlos: Am 19. Februar postete er kommentarlos eine Reihe von grau-weißen Instagram-Fotos. Wie sich jetzt herausstellt: Es gibt keinen Grund zur Sorge – im Gegenteil.

Machine Gun Kelly: Darum ließ er seine Tattoos covern
US-Rapper Machine Gun Kelly ist eigentlich für seine zahlreichen Tattoos auf dem ganzen Körper bekannt. Doch jetzt machte der 33-jährige Musiker einen gewagten Schritt: Er ließ sich einen großen Teil seines Oberkörpers schwarz tätowieren.

Langsam und unzuverlässig: Deutschland hat das schlechteste Internet Westeuropas
Wie eine am 22.02. veröffentlichte Umfrage der Unternehmensberatung Deloitte unter 2.000 Bundesbürger:innen zeigt, schneidet Deutschland in punkto Internet unter den sieben bevölkerungsreichsten Ländern Westeuropas Deutschland am schlechtesten ab.

Postgesetz-Reform: Briefe verschicken wird länger dauern
Die geplante Reform des Postgesetzes könnte dazu führen, dass Briefe künftig später zugestellt werden dürfen als bisher. Nach der ersten Debatte im Bundestag am 21. Februar zeichnet sich ab, dass in diesem Punkt Konsens besteht, berichtet die dpa.

Fans begeistert: Russell Crowe kaum wiederzuerkennen
Oscarpreisträger Russell Crowe war in den letzten Jahren eigentlich für seinen Look mit zerzausten Haaren und Bart bekannt. Jetzt hat er einen neuen Look.

DIY Botox Alternativen: Leinsamen, ein Massagerät und Cyro Globes im Test
Botox-Behandlungen sind teuer, da sind Do-it-yourself Alternativen für daheim gern gesehen. Wir testen Leinsamen, eine elektrisches Massagegerät und Cryo Globes – alle drei versprechen eine ähnliche Wirkung wie Botox, doch funktioniert das auch?

„So froh“: Emotionale Worte von Amira über Oliver Pocher
Amira Pocher findet in ihrem Podcast emotionale Worte über Oliver Pocher als Vater für ihre Kinder.

Rot, scharf, würzig: Reporter Christoph bei der Chili-Ernte
Kein Land produziert mehr Chilis als Indien. Doch unter welchen Bedingungen werden die Früchte geerntet? Um das herauszufinden, hat „Galileo“-Reporter Christoph zwei Tage bei der Ernte mit angepackt und die Schoten gepflückt, getrocknet und gemahlt.

„taff“ Klatsch: Beyoncé schreibt mit ihrem Country-Album Geschichte
Beyoncé schreibt mit ihrem Country-Album Geschichte // Machine Gun Kelly hat jetzt ein riesen Blackout-Tattoo auf dem Oberkörper // „Rent a Comedian“ startet bei ProSieben und Joyn // Das große Promibacken in SAT.1

Sommer-Jobs: Freiwilligen-Arbeit im Ausland (Teil 1)
Wilde Tiere, frühes Aufstehen und harte Arbeit. So sieht der Alltag für Tausende junge Deutsche aus, die im Ausland Freiwilligen-Arbeit für den Klima- und Tierschutz leisten. Was treibt sie an, in ihrer Freizeit zu schuften und auch noch dafür zu bezahlen?
Forschende entwickeln neues Antibiotikum gegen multiresistente Keime
Ein Forschungsteam der Harvard-Universität hat ein neues synthetisches Molekül entworfen, das sich gegen multiresistente Keime eignet. Allein in Deutschland infizieren sich jedes Jahr im Schnitt eine halbe Million Menschen mit den MR-Erregern.

Martin Scorsese wird auf Berlinale mit Ehrenbär für Lebenswerk geehrt
Ein Hauch von Hollywood auf der Berlinale: Star-Regisseur Martin Scorsese gab sich die Ehre. Er erhielt den Ehrenbären für sein Lebenswerk.

Die verrücktesten Auftritte des Castings
Mit Spannung erwartet Heidi die Bewerber für das offene Casting zur 19. „Germany’s Next Topmodel“-Staffel. Die Männer und Frauen versuchen mit allen Mitteln aus der Menge herauszustechen, manchmal mit ungewöhnlichen Auftritten.

Hirnmasse wird kleiner: Suchtexperte warnt Jugendliche vorm Kiffen
Suchtexperte Rainer Thomasius ist ein Gegner der Cannabis-Legalisierung. Er warnt vor erheblichen Suchtentwicklungen bei Kindern und Jugendlichen. 17-jährige regelmäßige Cannabis-Konsumenten seien teilweise auf dem Entwicklungsstand von 13-Jährigen.